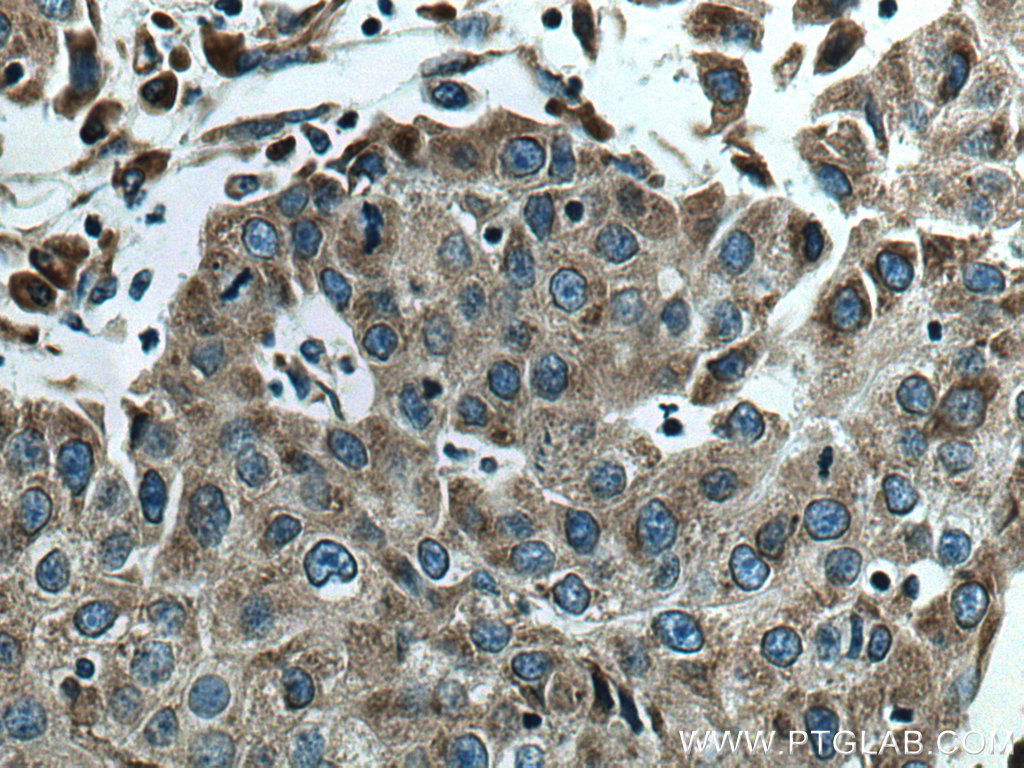
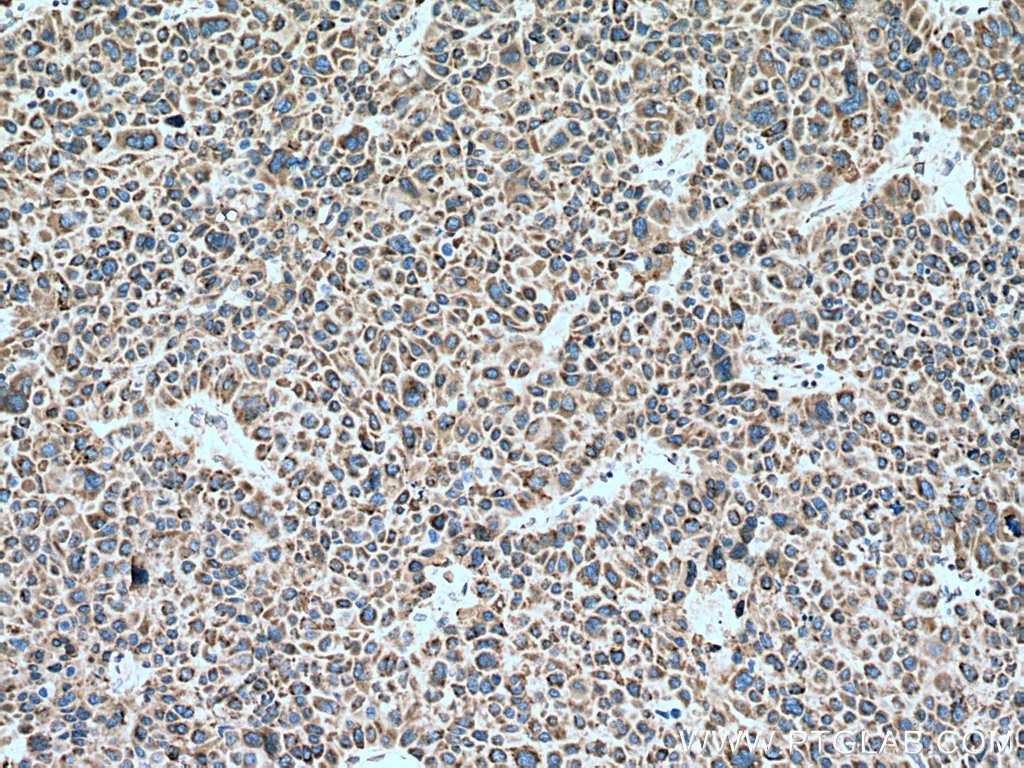

验证数据展示
经过测试的应用
| Positive WB detected in | A549 cells, pig brain tissue, HEK-293 cells, LNCaP cells, HeLa cells, HepG2 cells, Jurkat cells, MOLT-4 |
| Positive IHC detected in | human breast cancer tissue, human liver cancer tissue Note: suggested antigen retrieval with TE buffer pH 9.0; (*) Alternatively, antigen retrieval may be performed with citrate buffer pH 6.0 |
| Positive IF/ICC detected in | HeLa cells |
推荐稀释比
| 应用 | 推荐稀释比 |
|---|---|
| Western Blot (WB) | WB : 1:5000-1:50000 |
| Immunohistochemistry (IHC) | IHC : 1:1000-1:4000 |
| Immunofluorescence (IF)/ICC | IF/ICC : 1:200-1:800 |
| It is recommended that this reagent should be titrated in each testing system to obtain optimal results. | |
| Sample-dependent, Check data in validation data gallery. | |
产品信息
67329-1-Ig targets GSK3B in WB, IHC, IF/ICC, CoIP, ELISA applications and shows reactivity with human, pig samples.
| 经测试应用 | WB, IHC, IF/ICC, ELISA Application Description |
| 文献引用应用 | WB, IF, CoIP |
| 经测试反应性 | human, pig |
| 文献引用反应性 | human, mouse, rat |
| 免疫原 |
CatNo: Ag17320 Product name: Recombinant human GSK3B protein Source: e coli.-derived, PET28a Tag: 6*His Domain: 355-433 aa of BC000251 Sequence: ELRDPNVKLPNGRDTPALFNFTTQELSSNPPLATILIPPHARIQAAASTPTNATAASDANTGDRGQTNNAASASASNST 种属同源性预测 |
| 宿主/亚型 | Mouse / IgG1 |
| 抗体类别 | Monoclonal |
| 产品类型 | Antibody |
| 全称 | glycogen synthase kinase 3 beta |
| 别名 | GSK3 beta, GSK-3 beta, GSK 3 beta, EC:2.7.11.26, EC:2.7.11.1 |
| 计算分子量 | 433 aa, 48 kDa |
| 观测分子量 | 46-48 kDa |
| GenBank蛋白编号 | BC000251 |
| 基因名称 | GSK3B |
| Gene ID (NCBI) | 2932 |
| RRID | AB_2882588 |
| 偶联类型 | Unconjugated |
| 形式 | Liquid |
| 纯化方式 | Protein G purification |
| UNIPROT ID | P49841 |
| 储存缓冲液 | PBS with 0.02% sodium azide and 50% glycerol, pH 7.3. |
| 储存条件 | Store at -20°C. Stable for one year after shipment. Aliquoting is unnecessary for -20oC storage. |
背景介绍
Glycogen synthase kinase-3 (GSK3) is a proline-directed serine-threonine kinase that was initially identified as a phosphorylating and inactivating glycogen synthase .GSK3B is involved in energy metabolism, neuronal cell development, and body pattern formation.In skeletal muscle, it contributes to insulin regulation of glycogen synthesis by phosphorylating and inhibiting GYS1 activity and hence glycogen synthesis. Researches showed that the crystal structure of human GSK3B, expressed in insect cells, at 2.8-angstrom resolution .
实验方案
| Product Specific Protocols | |
|---|---|
| IF protocol for GSK3B antibody 67329-1-Ig | Download protocol |
| IHC protocol for GSK3B antibody 67329-1-Ig | Download protocol |
| WB protocol for GSK3B antibody 67329-1-Ig | Download protocol |
| Standard Protocols | |
|---|---|
| Click here to view our Standard Protocols |
发表文章
| Species | Application | Title |
|---|---|---|
Adv Mater Noninvasive Optogenetics Realized by iPSC-Derived Tentacled Carrier in Alzheimer's Disease Treatment | ||
Phytomedicine Deoxyshikonin from Arnebiae Radix promotes hair growth by targeting the Wnt/β-catenin signaling pathway | ||
J Ethnopharmacol Mechanism of Buyang Huanwu Decoction mediating Cav1-regulated Wnt pathway to promote neural regeneration in cerebral ischemic mice | ||
Mol Nutr Food Res Douchi Peptides Vy and Sfllr Improve Glucose Homeostasis and Gut Dysbacteriosis In High-Fat Diet-Induced Insulin Resistant Mice | ||
Mol Neurobiol Treadmill Exercise Modulates the Leptin/LepR/GSK-3β Signalling Pathway to Improve Leptin Sensitivity and Alleviate Neuroinflammation in High-Fat Diet-Fed APP/PS1 Mice | ||
J Inflamm Res Exogenous Plant gma-miR-159a, Identified by miRNA Library Functional Screening, Ameliorated Hepatic Stellate Cell Activation and Inflammation via Inhibiting GSK-3β-Mediated Pathways. |